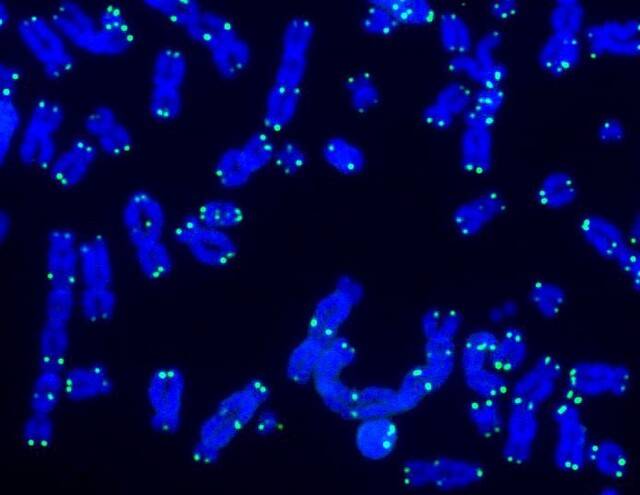
텔로미어는 세포가 분열할 때 서로 다른 염색체들이 섞이지 않도록 조절하고 염색체의 끝이 손상되지 않도록 보호하는 역할을 한다. 이미지는 DNA 복구 활동이 이뤄질 때의 텔로미어(녹색)와 DNA(파란색)의 모습. 사진제공=솔트연구소

불로장생의 열쇠…‘텔로미어’의 비밀 풀렸다
전체 맥락을 이해하기 위해서는 본문 보기를 권장합니다.
노화를 늦추고 더 오래 건강하게 사는 '불로장생'은 자연의 섭리를 거스르는 이뤄질 수 없는 꿈일까.
특히 최근에는 유전체편집을 적용할 대상으로 여겨지는 텔로미어(Telomere)와 미토콘드리아(Mitochondria)가 세포 염증을 일으키는 상호작용을 규명한 연구결과가 발표돼 주목받고 있다.
이 글자크기로 변경됩니다.
(예시) 가장 빠른 뉴스가 있고 다양한 정보, 쌍방향 소통이 숨쉬는 다음뉴스를 만나보세요. 다음뉴스는 국내외 주요이슈와 실시간 속보, 문화생활 및 다양한 분야의 뉴스를 입체적으로 전달하고 있습니다.
미국 연구팀 “노화를 일으키는 텔로미어와 미토콘드리아의 ‘세포 살해’ 과정 규명”
노화를 늦추고 더 오래 건강하게 사는 ‘불로장생’은 자연의 섭리를 거스르는 이뤄질 수 없는 꿈일까. 아직 먼 미래의 일처럼 느껴지지만 전 세계 전문가들은 최근 긍정적인 의견을 내고 있다. 우리 몸의 특정 DNA를 제거하고 수정하는 ‘유전체편집(Genome Editing)’과 세포에서의 유전자 제거를 가능케 하는 크리스퍼(CRISPR) 유전자 편집기술(일명 ‘유전자 가위’)의 발달이 그 이유다.
특히 최근에는 유전체편집을 적용할 대상으로 여겨지는 텔로미어(Telomere)와 미토콘드리아(Mitochondria)가 세포 염증을 일으키는 상호작용을 규명한 연구결과가 발표돼 주목받고 있다.
미국 솔크 연구소(Salk Institute) 연구팀은 최근 텔로미어의 길이가 매우 짧아지면 미토콘드리아와 염증 신호를 주고받고, 이를 통해 텔로미어가 짧아져 ‘손상된 세포’를 제거하는 염증 반응을 일으키게 하는 신호 전달체계가 활성화된다는 점을 발견했다. 이 연구결과는 국제학술지 '네이처'에 8일(현지시간) 게재됐다. 솔크 연구소는 노벨 생리의학상의 요람이라 불리는 세계 5대 생명공학연구센터 가운데 하나다.
텔로미어는 세포핵에 있는 염색체 끝부분에 존재하는 특수한 입자로, 평소에는 염색체를 보호하고, 세포가 분열할 때 서로 다른 염색체들이 섞이지 않게 막는 역할을 한다. 그러나 세포분열 과정에서 염색체의 끝부분은 완전히 복제되지 않는다. 이 때문에 세포분열이 반복될수록 텔로미어는 점점 짧아져서 결국 소실된다.
의료계에서는 이러한 텔로미어의 소실이 세포노화를 일으키는 주된 원인으로, 인체의 노화 역시 텔로미어와 연관성이 큰 것으로 추정하고 있다. 특히 텔로미어가 짧아져 손상된 세포는 유전자 돌연변이를 쉽게 일으키고 암 세포로 변할 가능성이 높다. 이 때문에 학자들은 노화가 암 발생을 막기 위한 자연적인 현상으로 해석하기도 한다.

연구팀은 앞서 세포 내 쓰레기를 치우는 자가포식작용으로 손상된 세포가 제거된다는 사실을 밝힌 바 있다. 손상된 세포 제거는 우리 몸의 주요 면역반응 가운데 하나다. 손상된 세포가 무절제한 세포증식으로 늘어나 장기나 혈액으로 침투하는 게 암이 발생하는 주된 원인이기 때문.
연구팀은 손상된 세포의 제거 과정을 명확히 확인하기 위해 사람 피부의 섬유아세포를 활용해 텔로미어가 매우 짧아지는 '세포 위기'가 발생할 때 세포 사멸이 촉발되는 과정을 인위적으로 반복했다.
그 결과 연구팀은 텔로미어의 길이가 짧아지면 미토콘드리아와의 상호작용으로 미토콘드리아 표면에 있는 ZBP1와 MAVS 두 종류의 단백질이 활성화되고, 이를 통해 세포를 제거하는 것을 발견했다. 제거할 세포를 찾는 역할을 하는 ZBP1 단백질이 기능이 손상된 텔로미어에서 합성되는 특정 RNA와 결합할 때 활성화되고, 미토콘드리아 외벽에서 선천면역기능을 하는 MAVS 단백질이 작동해 염증 반응을 일으켜 손상된 세포 제거과정을 규명한 것.
미토콘드리아는 모든 진핵세포에 존재하는 세포소기관으로, 세포 내 에너지를 공급하는 역할을 한다. 특히 자체 DNA를 가지고 있는 게 특징이다.
제럴드 샤델 솔크연구소 분자세포생물학 연구실장은 “텔로미어의 손실과 미토콘드리아의 기능이상, 염증 반응은 인간의 노화 과정에서 나타나는 대표적인 특징이지만 지금까지는 주로 따로 연구됐다”며 “이번 연구는 노화와 건강증진 연구를 위해선 이 같은 특징들 간 상호작용을 연구할 필요가 있음을 보여준다"고 설명했다. 연구팀은 향후 텔로미어와 미토콘드리아 간 분자전달 경로를 밝혀내면서 노화와 암 예방을 위한 치료법을 탐색할 계획이다.
Copyright © 농민신문. 무단전재 및 재배포 금지.